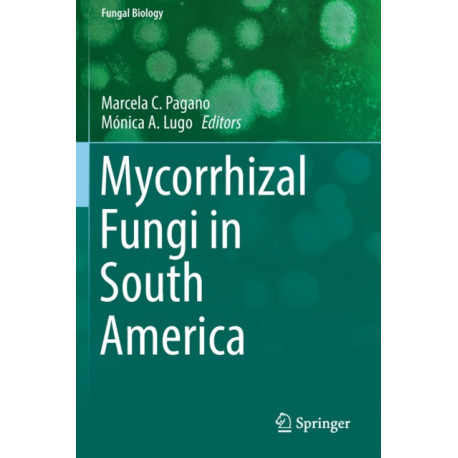

Kurv
Vare
varer
(tom)
Ingen varer
Fastlægges senere
Forsendelse
0,- kr
I alt
Mycorrhizal Fungi in South America
(Bog, Paperback / softback, Engelsk)
Forlag:
Springer Nature Switzerland AG
- Type: Bog
- Format: Paperback / softback
-
Sprog:
Engelsk

- ISBN-13: 9783030152307
- Se flere detaljer ▼
Bemærk: Kan ikke leveres før jul.
Beskrivelse
In these environments, different mycorrhizal associations (arbuscular / ericoid / orchidoid / ectomycorrhizal / mycoheterotrophic) are present in herbaceous plants, shrubs, and trees.
Læsernes anmeldelser (0)
Alle detaljer
| Forlag | Springer Nature Switzerland AG |
| Type | Bog |
| Format | Paperback / softback |
| Sprog | Engelsk |
| Udgave | 2019 ed. |
| Udgivelsesdato | 14-08-2020 |
| Første udgivelsesår | 2020 |
| Serie | Fungal Biology |
| Illustrationer | 51 Illustrations, color; 15 Illustrations, black and white |
| Fagredaktør | Marcela C. Pagano, Monica A. Lugo |
| Originalsprog | Switzerland |
| Sideantal | 374 |
| Indbinding | Paperback / softback |
| Forlag | Springer Nature Switzerland AG |
| Sideoplysninger | 374 pages, 51 Illustrations, color; 15 Illustrations, black and white |
| Mål | 235 x 155 |
| ISBN-13 / EAN-13 | 9783030152307 |

